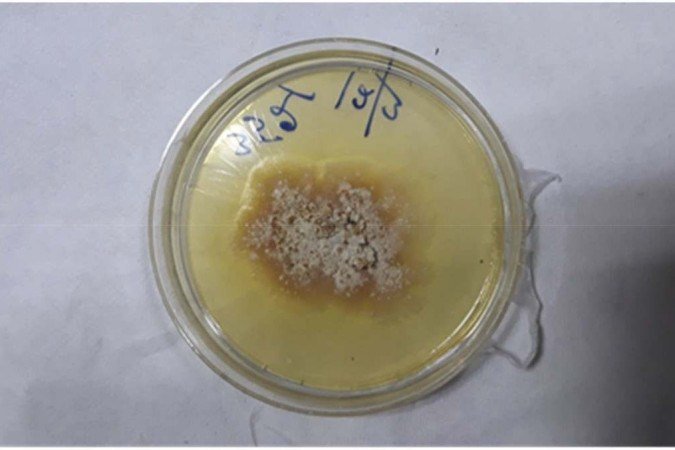

A epidemia zumbi retratada pela nova série da HBO, The Last Of Us, parece não ser mais uma realidade tão distante. Na produção, a população mundial é afetada por um fungo mortal que originalmente era capaz de afetar somente plantas e insetos, mas, após mutações, se tornou capaz de infectar seres humanos. A doença em questão seria causada pelo fungo Ophiocordyceps unilateralis, comumente chamado de fungo zumbi. Apesar de não se tratar do mesmo micro-organismos, a contaminação humana por fungos de plantas não é mais um cenário impossível. Pela primeira vez, um homem, de 61 anos, foi infectado por um fungo de planta assassina, na Índia.O drama apocalíptico do streaming tomou muitas liberdades dramáticas, como é natural em uma série de ficção, mas serviu para aumentar a conscientização da população sobre os riscos da infecção humana. Agora, o caso registrado na Índia acende mais um alerta: os perigos da ação do aquecimento global sobre fungos vegetais, uma vez que as mudanças climáticas contribuem para que esses fungos se adaptem melhor dentro do organismo das pessoas, já que diminuem a diferença de temperatura entre a natureza e o corpo humano.10 fatos fascinantes sobre a vida secreta dos fungos
O indiano infectado por um desses fungos, que não foi identificado, é micologista de plantas e trabalha com material em decomposição, cogumelos e vários fungos de plantas. Os médicos do Consultant Apollo Multispecialty Hospitals, em Calcutá, onde o homem foi tratado, diagnosticaram ele com Chondrostereum purpureum, que causa a doença das folhas prateadas nas plantas.Ele chegou ao hospital com sintomas semelhantes aos da gripe, que incluem rouquidão, tosse, faringite recorrente , fadiga, dificuldade de deglutição e anorexia por três meses. Sem histórico algum de doenças, o que poderia ser considerado um fator de risco para contaminação fúngica, o indiano foi submetido a exames que identificaram um abscesso paratraqueal no pescoço do paciente, que estava obstruindo suas vias aéreas.Esses abscessos podem levar a infecções com risco de vida, que podem ser fatais se não forem detectadas e tratadas rapidamente. Em um procedimento cirúrgico, os médicos conseguiram remover o pus e enviaram para o centro colaborador da Organização Mundial da Saúde (OMS) no norte da Índia para testes. Como tratamento, o micologista recebeu dois medicamentos antifúngicos para tomar por dois meses.O que é o Chondrostereum purpureum
O Chondrostereum purpureum é um fungo patógeno que causa a doença da folha prateada em árvores. Ele ataca a maioria das espécies de rosas da família Rosaceae, especialmente árvores e arbustos do gênero chamado Prunus, que inclui, entre muitos outros, as plantas que dão ameixas, cerejas, pêssegos, nectarinas, damascos e amêndoas.A infecção mortal por fungo que se espalha pelos EUA
Descobertas as moléculas “Keanu Reeves”, armas mortais na luta contra fungos
Nas plantas, a folha de prata é uma doença progressiva e, muitas vezes, fatal. O nome se dá porque, ao ser infectada, a árvore sofre uma mudança de coloração nas áreas afetadas e ficam prateadas. Esse fundo é espalhado por partículas transportadas pelo ar.Segundo os pesquisadores que estudaram o caso do indiano infectado, até o momento, não havia evidências de que humanos pudessem ser infectados por esse fungo em particular. “Este caso destaca o potencial de fungos de plantas ambientais para causar doenças em humanos”, alertaram os médicos em artigo publicado na revista Medical Mycology Case Reports.De acordo com o relato do caso, publicado na revista médica, o aquecimento global é um fator preocupante que pode “ser responsável pelo surgimento não apenas de infecções fúngicas mais recentes, mas também de várias doenças virais e bacterianas zoonóticas”. “O agravamento do aquecimento global e outras atividades da civilização abrem a Caixa de Pandora para novas doenças fúngicas”, ressaltaram os médicos.“O fato de doenças animais e humanas poderem ser causadas por patógenos de plantas é um novo conceito que levanta sérias questões sobre a propensão de tal infecção ocorrer tanto em indivíduos saudáveis quanto em indivíduos imunocomprometidos. Se os fungos podem escapar da via de fagocitose [processo pelo qual a célula ingere partículas grandes] e são capazes de escapar do sistema imunológico do hospedeiro, eles podem se estabelecer como patógenos humanos”, explicaram os pesquisadores.Os médicos salientaram ainda que há o risco de esses fungos penetrarem o corpo humano e causarem infecções, principalmente em pessoas com sistema imunológico frágil. “Essas espécies de fungos que são capazes de crescer a 35-37°C podem se tornar um patógeno humano ou uma flora comensal [microbioma humano]. O patógeno entra no corpo humano através da pele danificada e do trato respiratório e pode causar infecção principalmente em indivíduos imunocomprometidos”, concluíram.Fonte: Correio Braziliense






